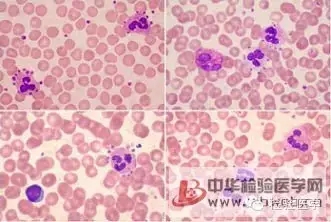

海博微信公众号
海博微信公众号
 海博天猫旗舰店
海博天猫旗舰店


 海博微信公众号
海博微信公众号
 海博天猫旗舰店
海博天猫旗舰店




流感嗜血杆菌的卫星现象

概念:当将金黄色葡萄球菌与流感嗜血杆菌在同一血琼脂平板上共同培养时,由于前者能合成较多的V因子,促进后者生长,故在金黄色葡萄球菌菌落周围生长的流感嗜血杆菌菌落较大,距离越远的菌落越小,此现象称为“卫星现象”。
方法:挑取可疑菌落密涂划种于血平板上和M-H平板上,再将金黄色葡萄球菌点种或划种于其上,35℃孵育24 h。
结果:如葡萄球菌菌落邻近处被检菌的菌落较大,远离葡萄球菌落邻近处被检菌的菌落较大,远离葡萄球菌菌落处的菌落小或不生长,即卫星试验阳性。
注意点:在血平板上点种葡萄球菌时,X、V因子都具备; 在M-H平板上接种葡萄球菌时,只具备V因子;流感嗜血杆菌生长需要X和V因子; 副流感嗜血杆菌生长只需要V因子。
意义:能在M-H平板上呈卫星生长的菌为副流感嗜血杆菌,不能在M-H平板上呈卫星生长的菌为流感嗜血杆菌。
血小板的卫星现象
使用EDTA-2K抗凝,少数患者血涂片尾部可以看到簇状聚集的血小板,有时还可以看到血小板粘附于白细胞周围,形成所谓的“血小板卫星”,导致血细胞分析仪计数的血小板偏低。
EDTA诱导“血小板卫星现象”,引起假性血小板减少即EDTA依赖性血小板减少症(PTCP)应该受到广泛重视,临床发生率约为0.09%~0.21%。
由于用EDTA盐(EDTA盐干粉抗凝剂,乙二胺四乙酸)干粉抗凝剂,在作为免疫介导的血液中,可出现的冷抗血小板自身抗体,使血小板互相凝集现象。这种EDTA依赖的冷抗血小板自身抗体,直接作用于血小板膜糖蛋白IIb/IIIa上。同时,这种与血小板结合的自身抗体Fc端可与单核细胞或淋巴细胞膜上Fc受体结合,出现卫星现象。引起血小板聚集出现卫星现象后,在全自动血细胞计数仪上检测时,发生假性血小板计数减少的现象。
原因有以下几点:
1.血凝出现问题。可能是抗凝比例不对,过高会导致卫星现象。
2.放置时间过短。这也是在25分钟之内测试分类不好血小板不稳的重要原因,EDTA抗凝剂与血小板凝血因子反应结合需要时间,这个时间随着温度的升高而缩短,这也就是天气变冷的时候容易出现问题的原因。
3.“血小板卫星现象”的原因还与血小板表面存在某种隐匿性抗原有关。只有当EDTA存在的条件下,机体的IgG 或者IgM抗体可以对血小板的某些表位发生反应。EDTA可引起血小板糖膜(GP)发生改变,即血小板形态发生变化,由正常的圆盘状变为圆球形,改变了血小板膜表面某种隐匿性抗原构象。部分病人血浆中存在的某种自身抗体与这种改变构象的抗原结合后的抗原抗体复合物激活了细胞膜中的磷酯酶,使血小板膜水解并释放胶原、凝血酶原等血小板活性物质。这些血小板活性物质都能不同程度的活化血小板纤维蛋白原受体(FIR-B),促使血小板与纤维蛋白原受体结合后聚集成团,导致血小板假性减少。
下一篇:食品中微生物鉴定技术的发展历程



